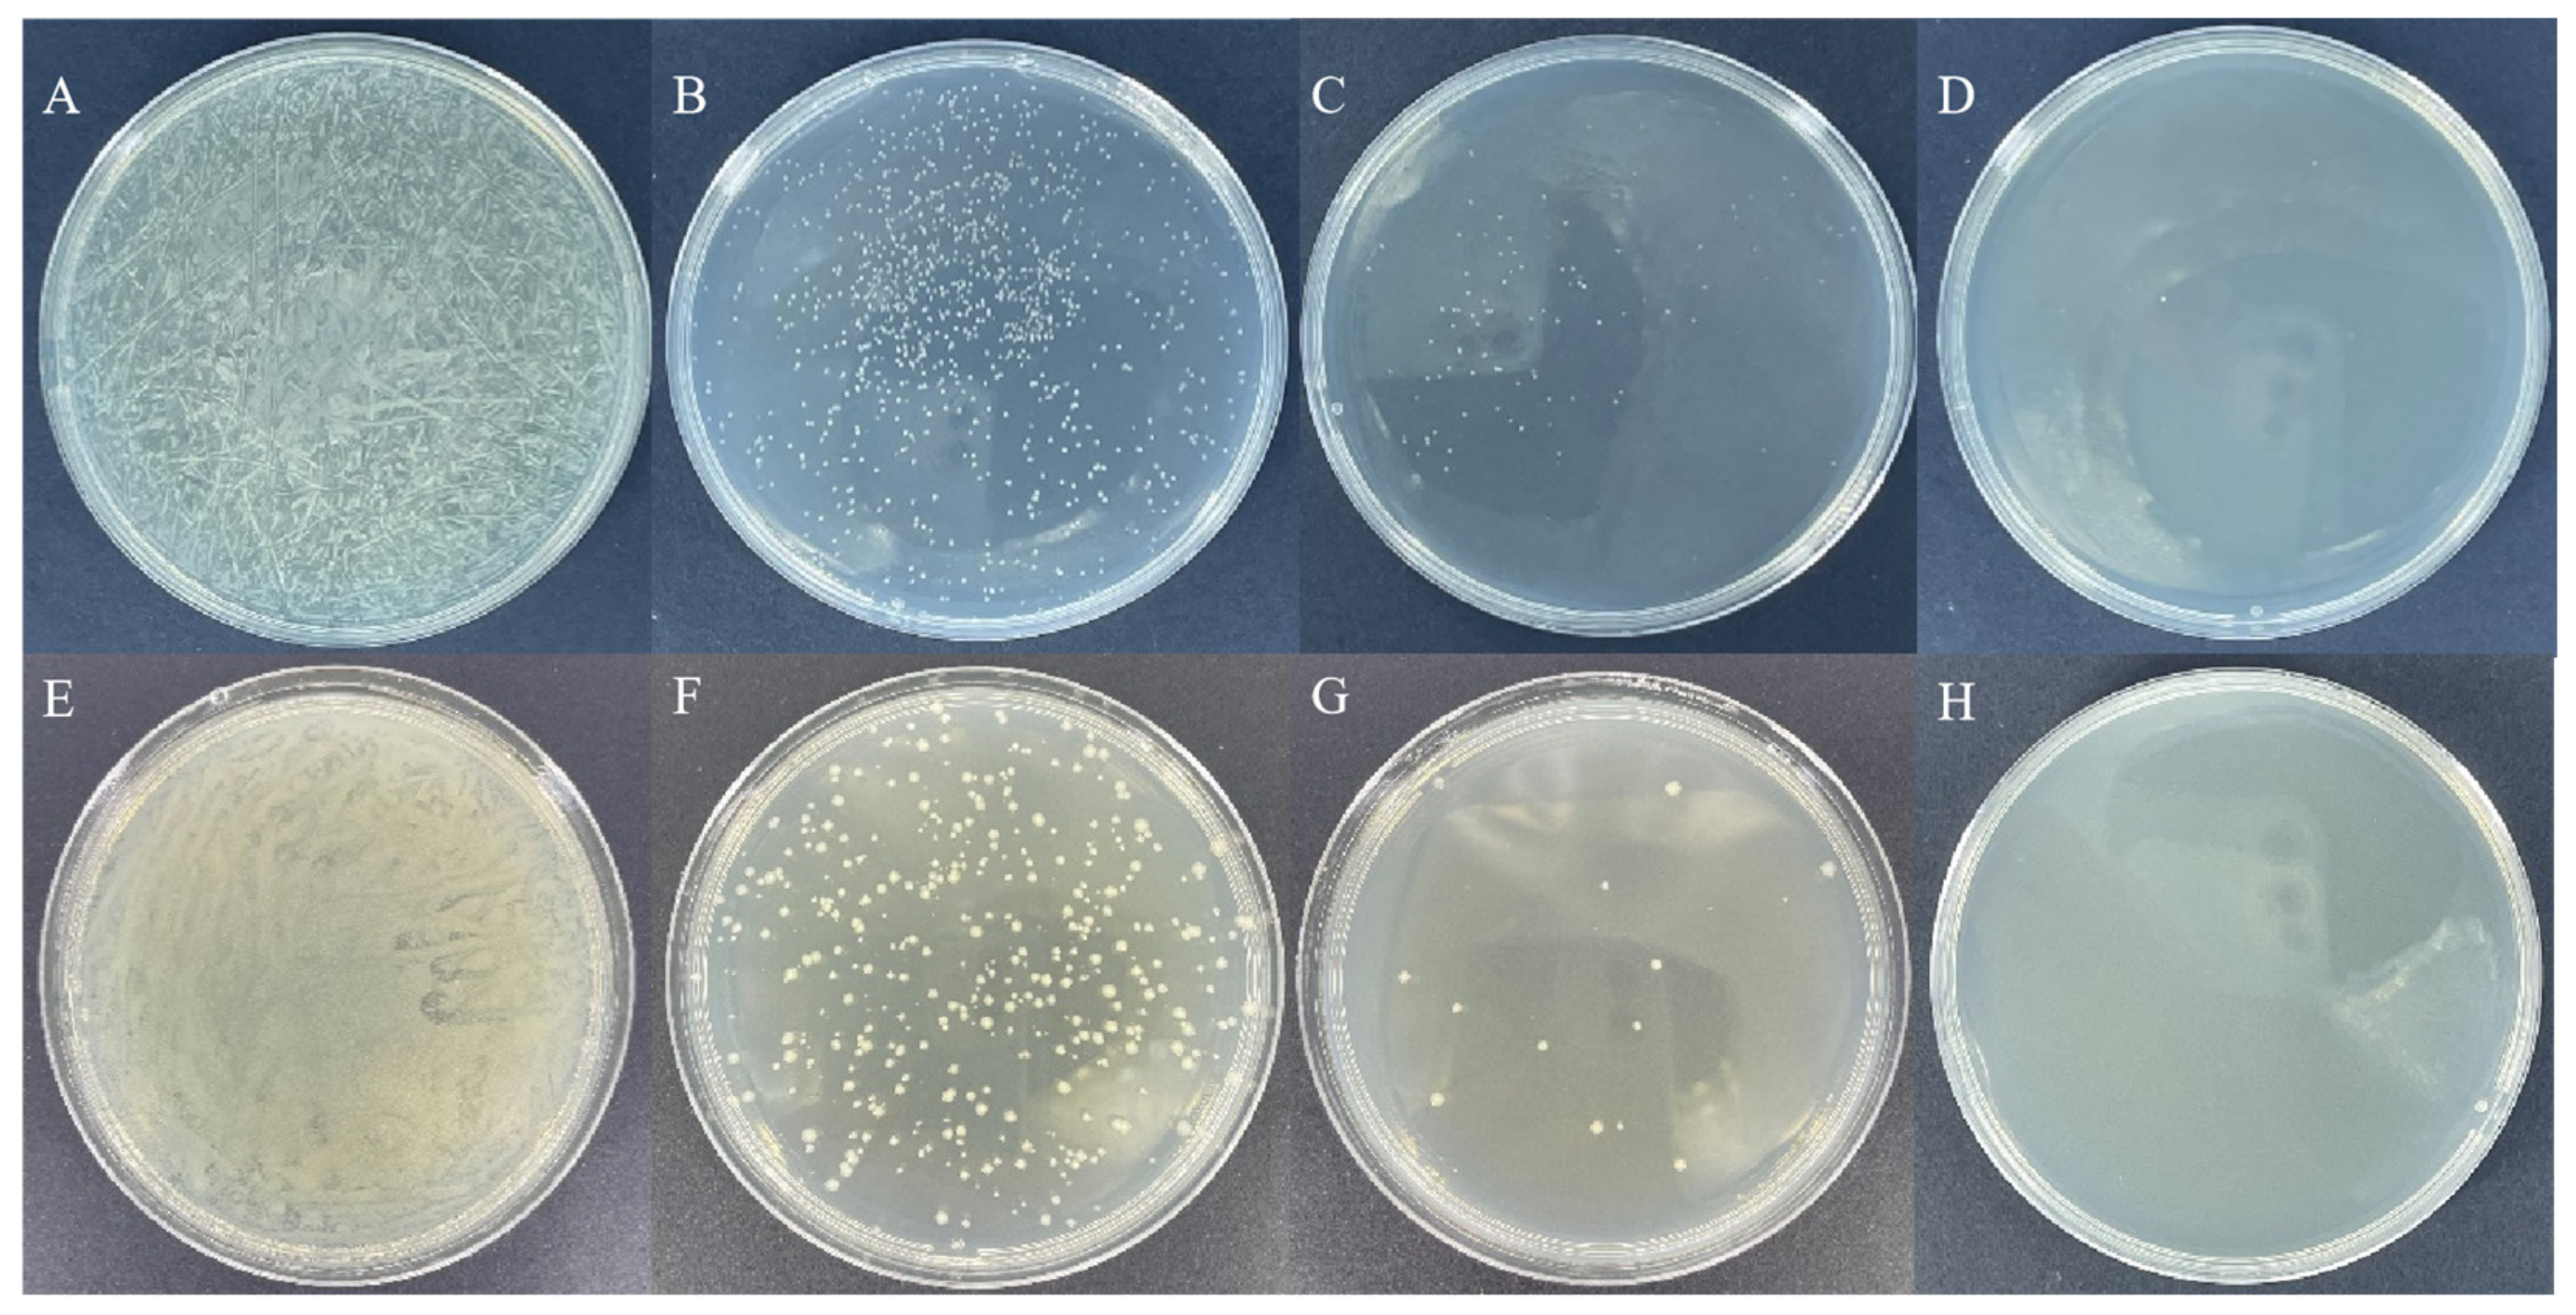
Insects 14 00140 g001 Insects 14 00140 g001

Simple Summary
Reticulitermes chinensis Snyder is an important pest that destroys trees and buildings and causes great damage. The present study investigated the role of RcOrco. A method for preparing large amounts of dsRNA using sonication of engineered bacteria was established. The dsRNA produced using this method was ingested by R. chinensis via feeding, which decreased the expression level of RcOrco and survival rate. The results of this study enhance our knowledge of orco function in social insects and propose new potential targets for termite control.
Abstract
Reticulitermes chinensis Snyder is a serious pest in China, and the odorant receptor co-receptor gene RcOrco plays a crucial role in olfaction. However, the function of RcOrco in the resistance of termites to entomopathogens has not been reported. We constructed dsRcOrco-HT115 engineered bacteria based on the RcOrco sequence from the full-length transcriptome data of R. chinensis. The engineered bacteria expressed dsRNA of RcOrco. Sonication was used to inactivate the dsRNA-HT115 strain and obtain a large amount of dsRcOrco. The dsRcOrco produced using this method overcame the problem that genetically engineered bacteria could not be applied directly and improved its effectiveness against termites. Bioassays using the dsRcOrco generated using this method showed that dsRcOrco significantly increased the toxicity of the bacterial and fungal pathogens to R. chinensis. The present study showed, for the first time, the function of Orco in termite resistance to pathogens, and the results provide a theoretical basis for the development and application of termite RNA biopesticides.
1. Introduction
Insects use their olfactory system to recognize various odorants in their environment to find food, mates, and avoid natural enemies [1]. Odors are primarily detected by odorant receptors (ORs) expressed on olfactory receptor neurons (ORNs) that project to the central nervous system [2]. ORs are essential in olfaction and are divided into two subclasses, the traditional OR and odorant receptor co-receptor (Orco) [3]. ORs convert chemical stimuli into electrical signals [4] to play an important role in the odor recognition process. Orco and ORs form an Orco-OR heterotetramer that constitutes a ligand-gated ion channel [5]. Orco is highly conserved and plays an essential role in insect olfaction. Traditional ORs cannot function alone in the absence of Orco, and the absence of Orco impairs olfaction and olfactory behavior. For example, the knockout of Orco reduced olfactory sensitivity and affected insect behavior and physiology [6,7]. Orco mutations in mosquitoes, Protaetia brevitarsis (Lewis), resulted in an inability to find hosts and impaired responses to odorants such as sex pheromones and volatiles [8,9]. Blattella germanica (L.) responded slowly to odorants from food after Orco was silenced [10]. Orco mutation ants exhibited a behavioral phenotype with loss of the olfactory system and reduced response to odorants [11]. Termite workers have limited visual capabilities and communicate with nest mates primarily via olfactory channels to convey pheromonal and other chemical cues. Knockout of the Orco gene affects the ability of Odontotermes formosanus (Shiraki) to discriminate between nestmates, which increased aggression toward nest mates [12]. Previous studies on the functions of Orco have mostly focused on foraging, mating, and host selection. However, whether Orco affects insect resistance to pathogens is not clear.
RNAi is a widely used tool to study gene function, and it has shown great potential in developing new pest management strategies [13]. RNAi is a sequence-specific gene silencing phenomenon induced by double-stranded RNA (dsRNA) at the post-transcriptional level, and it has been used to study different species of insects, including Lepidoptera, Hymenoptera, and Diptera [14]. It is feasible to research the function of termite genes by feeding or injecting synthetic dsRNA [15,16,17]. DsRNA is considered a new generation of RNA biopesticides with great potential for biological control. For example, feeding Spodoptera littoralis (Boisduval) larvae sl 102 dsRNA enhanced the toxicity of Bt [18]. The use of specific dsRNA feeding to silence termicin and GNBP genes in Reticulitermes flavipes (Kollar) reduced the survival of termites infected with pathogens [19]. Silencing of the β-1,3-glucan binding protein gene effectively increased the susceptibility of Plutella xylostella (L.) to entomopathogenic fungi [20]. The dsRNA or siRNA used in these studies was prepared directly by in vitro synthesis or by extracting the expressed dsRNA from the engineered bacteria using chemical reagents (e.g., TRIzol or phenol) [21]. These methods are expensive or time-consuming, which is not conducive to large-scale application in dsRNA production.
Reticulitermes chinensis Snyder is a serious pest that damages forests and buildings. It is widely distributed in China and causes huge economic losses annually [22]. Although some researchers hope to only use pathogenic bacteria to control R. chinensis, Chouvenc et al. have demonstrated that it is not feasible to control termites by using microorganisms alone. Instead, by focusing research on understanding the complex biology of termites, particularly their various defense mechanisms, investigators may find a way for pathogens to bypass such mechanisms, and improve prospects for biological control [23]. Therefore, the combination of pathogenic bacteria and RNAi is the development direction of termite biological control. The silencing of Orco in R. chinensis impaired their olfaction. However, whether Orco silencing in R. chinensis affects their responses to pathogen infections is not known. The present study constructed dsRNA-HT115 bacteria and sonicated them to produce a large amount of dsRcOrco for direct application. We used the dsRcOrco produced by this method to investigate whether Orco played an important role in the defensive responses of R. chinensis to entomopathogen infection. The present study provides a basis for the development and application of termite RNA biopesticides. Furthermore, the results provide a theoretical basis for the association of RNAi of termites with pathogens.
2. Materials and Methods
2.1. Insects and Microorganisms
The R. chinensis termites used in this study were collected from six colonies in Jiangsu Province, China, and were maintained separately in plastic containers (20 cm × 15 cm × 15 cm). The colonies were maintained at 25 ± 1 °C, 90% ± 5% relative humidity, and 24 h darkness. Only healthy workers were selected for the experiment.
Ten microliters of preserved Serratia marcescens Bizio (SM1) were dropped into 50 mL of fermentation medium and incubated at 30 °C and 180 rpm for 48 h. Bacillus thuringiensis Berliner (Bt) was cultured in LB medium at 37 °C and 180 rpm for 1 week. Beauveria bassiana (Bals.-Criv.) Vuill. (Bb) was incubated in a PDA medium for 2 weeks at 30 °C. A spore suspension was prepared by rinsing B. bassiana spores in the medium using 0.1% Tween 80.
2.2. Synthesis of dsRNA
The RcOrco gene sequence (1418bp) was obtained from the full-length transcriptome data of R. chinensis (Table S1). Total RNA was extracted from 100 mg of termite worker antennae using TaKaRa RNAiso Plus (TRIzol) according to the manufacturer’s protocol. The extracted total RNA was reverse transcribed to cDNA using the PrimescriptTM 1st Strand cDNA Synthesis Kit (Takara, Dalian, Liaoning, China). Based on the ORF of the RcOrco gene, a pair of specific amplification primers (Table S2) was designed by predicting the possible RNAi sites using the online website (http://sidirect2.RNAi.jp/ accessed on 20 December 2022), and PCR amplification was performed with the designed primers. The PCR products were identified using 1% agarose gel electrophoresis, and the target fragments were recovered using a Gel Extraction Kit. The PCR product was ligated to the L4440 vector via double digestion and ligation with T4 DNA ligase. The ligated vector was transformed into HT115-competent cells. After sequencing was confirmed, the transformed HT115 bacteria were cultured at 37 °C overnight and stored in 25% bacterial fluid + 75% glycerol at −80 °C and recorded as dsRcOrco-HT115. GFP was used as a control for the same methodology as above, and the dsGFP-producing strain was recorded as dsGFP-HT115.
2.3. Inactivation of dsRNA-HT115 by Sonication for dsRNA Preparation
Ten microliters of preserved dsRcOrco-HT115 bacteria were added to 50 mL of liquid Luria–Bertani (LB) broth, and ampicillin and tetracycline were added to final concentrations of 75 μg/mL and 12.5 μg/mL, respectively. The bacterial solution was cultured at 37 °C for 24 h with shaking (180 rpm). One milliliter of the bacterial solution was added to 50 mL of LB liquid medium, and the concentrations of ampicillin and tetracycline in the medium were the same as listed above. The solutions were incubated with shaking at 37 °C until the OD600 = 0.4–0.6, then 400 μL isopropyl-beta-D -thiogalactopyranoside (IPTG, a final concentration of 0.8 mM) was added to induce the expression of dsRNA. The bacteria were incubated at 37 °C with shaking for 4 h. Sonication treatment was used to kill the dsRNA-HT115 bacteria, and disrupting the cell wall and cell membrane of the bacteria promoted the release of dsRNA. Eight milliliters of dsRcOrco-HT115 bacteria were centrifuged at 12,000 rpm for 5 min, the supernatant was removed, and 5 mL of DEPC water was added and mixed well. The bacterial suspension was crushed using an ultrasound homogenizer with 50% power, 3 s on and 6 s off. One hundred microliters of the bacterial solution were aspirated every 20 min, added to LB medium (containing 100 μg/mL ampicillin and 12.5 μg/mL tetracycline), and observed after 24 h.
2.4. Establishment of the Standard Curve for dsRcOrco
IPTG was added to the dsRNA-HT115 bacterial solution at a final concentration of 0.8 mM. The bacterial solution was incubated at 37 °C for 4 h and centrifuged for 5 min (8500 rpm). The supernatant was removed, and dsRNA was extracted using TRIzol. The concentration of dsRNA was expressed by measuring the UV absorbance of the dsRNA solution at 260 nm. Real-time fluorescent quantitative PCR (qRT-PCR) was performed by diluting the starting solution containing 1000 ng/μL dsRNA in four gradients at a 10-fold dilution as a template, and primers were designed for qRT-PCR (Table S2), and the CT values obtained by qRT-PCR were plotted against the concentration of dsRNA to establish the standard curve of dsRNA. Using the absolute quantification method, the concentration of dsRNA in the inactivated solution was determined by correlating the CT values with the established standard curve to ensure the consistency of the concentration of dsRNA in the inactivated solution in RNAi experiments [24].
2.5. Interference Efficiency of dsRcOrco
Twenty worker termites were put into Petri dishes (7 cm) lined with dry filter paper, which was treated with 400 μL of dsRcOrco (1.5 μg/μL dsRNA) and Nile blue (1% w/v). dsGFP (1.5 μg/μL dsRNA) and Nile bule (1% w/v) were used as positive controls, and DEPC water and Nile blue (1% w/v) were used as negative controls. The termites were placed in darkness. The total RNA of termite workers collected at different treatment times was extracted using TRIzol, and primers were designed outside the dsRNA region (Table S2). The expression levels of the RcOrco gene of termites at different treatment times (6, 12, 24, and 48 h) were detected using qRT-PCR, and β-actin and HSP 70 were used as internal reference genes (Table S2). The qRT-PCR data were calculated using the 2-ΔΔCT method [25,26].
2.6. Bioassay of dsRNA Combined with Pathogens to R. chinensis
A number of R. chinensis workers for this experiment were placed into Petri dishes with dry filter paper containing 400 μL of dsRcOrco (1.5 μg/μL dsRNA) and Nile blue (1% w/v) (dsRcOrco treatment), DEPC water and Nile blue (1% w/v) (CK treatment), dsGFP (1.5 μg/μL dsRNA) and Nile blue (1% w/v) (dsGFP treatment) for 12 h. The workers from the CK, dsGFP, and dsRcOrco treatments were divided into two groups (uninfected and bacterial infection group), respectively. Two microliters of culture medium were placed on each worker’s pronotum [uninfected groups: CK (negative control), dsGFP (positive control), and dsRcOrco]; 2 μL of Bt (3.3 × 109 cells/mL) was applied to the pronotum of each worker termite that was dyed blue (bacterial infection groups: CK-Bt, dsGFP-Bt, and dsRcOrco-Bt). Three replicates were from three different colonies and recorded every 24 h. In addition, the processing and grouping method of 2 μL of SM1 (3.8 × 1011 cells/mL) or 2 μL of Bb spore suspension (4.9 × 109 cells/mL) was the same as Bt.
2.7. Statistical Analysis
InStat software (GraphPad, San Diego, CA, USA) was used to analyze the collected data. Two-tailed unpaired Student’s t-test was used to compare differences between the two samples. The statistical significance of multiple sample comparisons was determined using one-way ANOVA and Tukey’s HSD test. A p-value < 0.05 indicated a significant difference. RNAi bioassay data were analyzed using the log-rank Mantel-Cox test (GraphPad Prism 8.0.2, GraphPad Software, San Diego, CA, USA).
3. Results
3.1. Construction of Inactivated dsRNA-HT115 System for dsRNA Preparation
3.1.1. Inactivation of dsRcOrco-HT115
The bacterial solution was sonicated using an ultrasound homogenizer, and the samples were collected every 20 min. After ultrasonic treatment, the bacterial solution was plated in Petri dishes containing LB medium. The results showed that the number of colonies continued to decrease as the sonication time increased, and the Petri dishes no longer showed colonies after 1 h of sonication (Figure 1). Therefore, we used 1 h of sonication for subsequent experiments.

Figure 1.
Growth condition of dsRcOrco-HT115 on medium after sonication. dsRcOrco-HT115 (A–D) (A): 0 min. (B): 20 min. (C): 40 min. (D): 60 min. dsGFP-HT115 (E–H) (E): 0 min. (F): 20 min. (G): 40 min. (H): 60 min.
3.1.2. The Standard Curve for dsRcOrco
The logarithms of the four gradient concentrations were plotted against the corresponding CT values. The standard curve for dsRcOrco was calculated as y = −2.7754x + 13. 67 (R2 = 0.952) (Figure 2A), and the standard curve for dsGFP was established in the same manner as y = −2.9408 x + 15. 912 (R2 = 0.9505) (Figure 2B).

Figure 2.
Standard curves of dsRNA (A) dsRcOrco and (B) dsGFP.
3.1.3. Interference Efficiency of dsRcOrco
After dsRcOrco treatment, qRT-PCR was used to quantify the expression levels of the RcOrco gene at different treatment times. The results showed that the expression of RcOrco was suppressed at all time periods, and the transcript levels of the RcOrco gene decreased by 24.5%, 72.7%, 41.6%, and 55.5% at 6, 12, 24, and 48 h, respectively, with the greatest decrease in the transcript levels of the RcOrco gene at 12 h (Figure 3).

Figure 3.
The effect of dsRcOrco on the relative expression of RcOrco in R. chinensis. The letters above the columns indicate different expressive differences.
3.2. Effects of Three Pathogens on dsRNA-Treated R. chinensis
3.2.1. Bioassay of dsRcOrco Combined with Bt
The results of using Bt to treat termites after silencing RcOrco showed that the mortality rate of the dsRcOrco-Bt group (37.5%) was significantly higher (F = 46.2; df = 5.18; p < 0.0001) than the other treatment groups at 4 d (Figure 4A). The mortality rate of the dsRcOrco-Bt group (50%) was significantly higher (F = 23.4; df = 5.18; p < 0.0001) than the other treatment groups at 8 d (Figure 4B). The dsRcOrco-Bt group reached the highest mortality rate of 62.5% at 12 d, which was significantly higher (F = 48.305; df = 5.18; p < 0.0001) than the CK-Bt group (7.5%) and dsGFP-Bt group (17.5%) (Figure 4C). The results of the survival curves showed that the survival rate of the dsRcOrco-Bt group was lower than the other Bt treatment groups (CK-Bt group and dsGFP-Bt group), and the survival rate of the Bt treatment groups (CK-Bt, dsGFP-Bt, and dsRcOrco-Bt) was lower than other groups (CK group, dsGFP group, and dsRcOrco group) (Figure 4D).

Figure 4.
Bioassay of dsRcOrco combined with Bt in R. chinensis. (A) Mortality rate of each treatment group at 4 d. (B) Mortality rate of each treatment group at 8 d. (C) Mortality rate of each treatment group at 12 d. (D) Survival rate of each treatment group. The letters above the columns indicate different expressive differences.
3.2.2. Bioassay of dsRcOrco Combined with SM1
The results of using SM1 to treat termites after silencing RcOrco showed that the mortality rate of dsRcOrco-SM1 (F = 15.57; df = 5,18; p < 0.0001) was the highest among all treatment groups, reaching 25% at 4 d (Figure 5A). The mortality rate of the dsRcOrco-SM1 group was 35% at 8 d, which was 18.34% and 20% higher (F = 31.48; df = 5,18; p < 0.0001) than the CK-SM1 and dsGFP-SM groups, respectively (Figure 5B). The mortality rate of the dsRcOrco-SM1 treatment group at 12 d (F = 34.974; df = 5,18; p < 0.0001) was 26.67% and 28.33% higher than the CK-SM1 and dsGFP-SM1 groups, respectively (Figure 5C). The results of the survival curves showed that the survival rate of the dsRcOrco-SM1 group was lower than the other SM1 treatment groups (CK-SM1 group and dsGFP-SM1 group), and the survival rate of the SM1 treatment groups (CK-SM1, dsGFP-SM1, and dsRcOrco-SM1) was lower than other groups (CK group, dsGFP group, and dsRcOrco group) (Figure 5D).

Figure 5.
Bioassay of dsRcOrco combined with SM1 in R. chinensis (A) Mortality rate of each treatment group at 4 d. (B) Mortality rate of each treatment group at 8 d. (C) Mortality rate of each treatment group at 12 d. (D) Survival rate of each treatment group. The letters above the columns indicate different expressive differences.
3.2.3. Bioassay of dsRcOrco Combined with Bb
The results of using Bb to treat termites after silencing RcOrco showed that the mortality rate of the dsRcOrco-Bb group was 30% at 6 d (F = 10.986; df = 5,18; p = 0.0004), which was significantly higher than the CK-Bb group (15%) and the dsGFP-Bb group (10%) (Figure 6B), and the mortality rate of the dsRcOrco-Bb group was the highest at 37.5% at 9 d (F = 15.429; df = 5,18; p < 0.0001), which was higher than the dsGFP-Bb group and the CK-Bb group (Figure 6C). Survival curves showed that the survival rate of the dsRcOrco-Bb group was lower than the other Bb treatment groups (CK-Bb group and dsGFP-Bb group), and the survival rate of the Bb treatment groups (CK-Bb, dsGFP-Bb, and dsRcOrco-Bb) was lower than other groups (CK group, dsGFP group, and dsRcOrco group) (Figure 6D).

Figure 6.
Bioassay of dsRcOrco combined with Bb in R. chinensis. (A) Mortality rate of each treatment group at 3 d. (B) Mortality rate of each treatment group at 6 d. (C) Mortality rate of each treatment group at 9 d. (D) Survival rate of each treatment group. The letters above the columns indicate different expressive differences.
4. Discussion
One common approach to silence the expression of target genes in insect RNAi experiments is the injection of dsRNA or siRNA, but the use of microinjection may lead to higher mortality of small insects, such as termites. This methodology also requires additional equipment and techniques to perform, compared to the feeding method which requires a larger amount of dsRNA [27]. There are limitations in the application of engineered bacteria due to environmental safety concerns. Therefore, the engineered bacteria dsRNA-HT115 expressing dsRNA cannot be used directly, and feeding Spodoptera exigua (Hübner) dsRNA-engineered bacteria failed to improve insecticidal activity [28], which may be due to the continuous slow release of dsRNA after the engineered bacteria enter the insects and the low concentration of dsRNA that cannot effectively trigger RNAi [29]. However, sonication disrupts the cell wall and cell membrane of engineered bacteria to cause the release of dsRNA from the bacteria. The dsRNA that is released after sonication pretreatment of engineered bacteria significantly increased the mortality of Maruca vitrata (Fabricius) larvae [30]. The use of inactivated engineered bacteria to produce dsRNA has not been reported in termites. Our study used sonication-inactivated bacteria for RNAi experiments, which allowed for the rapid preparation of dsRNA in large quantities and provided technical support for the development of novel dsRNA biopesticides for termites and the use of inactivated bacteria expressing dsRNA to ensure environmental safety. Therefore, this method has broad application in pest control.
Social insects, such as bees, have a lower number of immune genes than solitary insects, such as mosquitoes and flies [31]. Despite these obvious weaknesses, social insects, such as bees, ants, and termites, cope well with pathogens, and termite nests are rarely destroyed by pathogenic microbial infections, which may be related to social immune strategies to avoid pathogenic infection. However, the number of genes for odorant receptors and gustatory receptors is significantly higher in social insects than in solitary insects [32,33], which may be because social insects have evolved to strengthen social immunity by enhancing their olfactory ability to compensate for the deficiency of humoral and cellular immunity and enhance the ability of the group to resist diseases. Termites can detect the presence of Metarhizium anisopliae (Metsch.) Sorokin at a distance via olfaction and avoid physical contact with pathogenic fungi [34]. Termites show a marked aversion to the odor of specific volatiles of Pseudomonas aeruginosa (Schroeter) Migula. When infected workers enter the nest, other workers recognize them and remove spores from the body surface of the infected workers by grooming behavior [35,36]. The termites also use high-frequency shaking to warn nest mates not to approach the infected worker termites [37,38]. The basis of these behavioral defenses is that termites accurately identify the odor of pathogens and infected individuals via olfaction. Therefore, the silencing of a key gene in termite olfactory recognition, Orco, will affect the olfaction of termites and disrupt and reduce their social immunity to pathogen infection.
RNAi specifically suppresses gene expression and has great potential for pest control [39]. The use of RNAi in combination with entomopathogens is an important aspect of biological control. The innate and social immunity of termites makes them resilient to most pathogens, and the use of RNAi technology to impair this immunity in combination with entomopathogens may be effective for biological control. Termicin silencing in O. formosanus termites using RNAi significantly increased the toxicity of SM1 [40]. Orco functions in host finding, foraging, courtship, mating, pheromone recognition, and other behaviors [4,10,11,41]. Termites are social insects with strong social immunity, and olfaction plays an important role in the social immunity process. Therefore, we used RcOrco as a target gene for RNAi to investigate its function in the resistance of R. chinensis termites to pathogen infection. Our results showed that RcOrco silencing significantly reduced termite survival when R. chinensis was infected with pathogens. The combination of dsRcOrco and pathogens significantly enhanced virulence. We suspect that the silencing of RcOrco with dsRcOrco impaired the ability of termites to accurately recognize the odors of pathogens, which may reduce the frequency of grooming behavior to remove pathogens and weaken the social immunity of termites to allow the pathogenic microorganisms to remain on the termite cuticle and enter the hemocoel. These suggested mechanisms must be explored in future studies.
5. Conclusions
In summary, the results showed that feeding termites with dsRcOrco obtained from inactivated engineered bacteria silenced the expression of Orco in R. chinensis, and silencing of the RcOrco gene enhanced the virulence of Bt, SM1, and Bb. Therefore, RcOrco plays an important role in the immunity of R. chinensis to pathogen infection, and it should be considered a potential target for the development of RNAi agents to control pests.
Supplementary Materials
The following supporting information can be downloaded at: https://www.mdpi.com/article/10.3390/insects14020140/s1, Table S1: The sequence of RcOrco. Table S2: Primers used for this study.
Author Contributions
Conceptualization, F.T.; methodology, F.T.; software, D.J.; validation, D.J., X.L. and L.Z.; formal analysis, D.J., X.L., L.Z. and F.T.; investigation, D.J.; data curation, D.J. and L.Z.; writing—original draft preparation, D.J.; writing—review and editing, F.T.; visualization, D.J.; supervision, F.T.; project administration, F.T.; funding acquisition, F.T. All authors have read and agreed to the published version of the manuscript.
Funding
This research was supported by The Natural Science Foundation of the Jiangsu Higher Education Institutions of China (grant number 20KJA220003) and the Priority Academic Program Development Fund of Jiangsu Higher Education Institutions. No additional external funding was received for this study.
Institutional Review Board Statement
Not applicable.
Informed Consent Statement
Not applicable.
Data Availability Statement
The data presented in this study are available on request from the corresponding author.
Acknowledgments
We thank Yinjuan Zhao (Nanjing Forestry University) for providing the Bacillus thuringiensis strain.
Conflicts of Interest
The authors declare no conflict of interest. The funders had no role in the design of the study; in the collection, analyses, or interpretation of data; in the writing of the manuscript; or in the decision to publish the results.
References
- Nehring, V.; Steiger, S. Sociality and communicative complexity: Insights from the other insect societies. Curr. Opin. Insect Sci. 2018, 28, 19–25. [Google Scholar] [CrossRef] [PubMed]
- Tsoumani, K.T.; Belavilas-Trovas, A.; Gregoriou, M.E.; Mathiopoulos, K.D. Anosmic flies: What Orco silencing does to olive fruit flies. BMC Genet. 2020, 21, 140. [Google Scholar] [CrossRef] [PubMed]
- Harini, K.; Sowdhamini, R. Molecular modelling of oligomeric states of DmOR83b, an olfactory receptor in D. melanogaster. Bioinform. Biol. Insights 2012, 6, 33–47. [Google Scholar] [CrossRef] [PubMed]
- Leal, W.S. Odorant reception in insects: Roles of receptors, binding proteins, and degrading enzymes. Annu. Rev. Entomol. 2013, 58, 373–391. [Google Scholar] [CrossRef] [PubMed]
- Butterwick, J.A.; Del Mármol, J.; Kim, K.H.; Kahlson, M.A.; Rogow, J.A.; Walz, T.; Ruta, V. Cryo-EM structure of the insect olfactory receptor Orco. Nature 2018, 560, 447–452. [Google Scholar] [CrossRef]
- Asahina, K.; Pavlenkovich, V.; Vosshall, L.B. The survival advantage of olfaction in a competitive environment. Curr. Biol. 2008, 18, 1153–1155. [Google Scholar] [CrossRef]
- Yi, X.; Zhao, H.M.; Wang, P.D.; Hu, M.Y.; Zhong, G.H. Bdor\Orco is important for oviposition-deterring behavior induced by both the volatile and non-volatile repellents in Bactrocera dorsalis (Diptera: Tephritidae). J. Insect Physiol. 2014, 65, 51–56. [Google Scholar] [CrossRef]
- Sun, H.; Liu, F.; Ye, Z.; Baker, A.; Zwiebel, L.J. Mutagenesis of the orco odorant receptor co-receptor impairs olfactory function in the malaria vector Anopheles coluzzii. Insect Biochem. Mol. Biol. 2020, 127, 103497. [Google Scholar] [CrossRef]
- Koutroumpa, F.A.; Monsempes, C.; François, M.C.; de Cian, A.; Royer, C.; Concordet, J.P.; Jacquin-Joly, E. Heritable genome editing with CRISPR/Cas9 induces anosmia in a crop pest moth. Sci. Rep. 2016, 6, 29620. [Google Scholar] [CrossRef]
- He, P.; Ma, Y.F.; Wang, M.M.; Wang, H.; Dewer, Y.; Abd El-Ghany, N.M.; Chen, G.L.; Yang, G.Q.; Zhang, F.; He, M. Silencing the odorant coreceptor (Orco) disrupts sex pheromonal communication and feeding responses in Blattella germanica: Toward an alternative target for controlling insect-transmitted human diseases. Pest Manag. Sci. 2021, 77, 1674–1682. [Google Scholar] [CrossRef]
- Yan, H.; Opachaloemphan, C.; Mancini, G.; Yang, H.; Gallitto, M.; Mlejnek, J.; Leibholz, A.; Haight, K.; Ghaninia, M.; Huo, L.; et al. An engineered orco mutation produces aberrant social behavior and defective neural development in ants. Cell 2017, 170, 736–747. [Google Scholar] [CrossRef] [PubMed]
- Sun, P.D.; Yu, S.X.; Merchant, A.; Lei, C.L.; Zhou, X.G.; Huang, Q.Y. Downregulation of Orco and 5-HTT alters nestmate discrimination in the subterranean termite Odontotermes formosanus (Shiraki). Front. Physiol. 2019, 10, 714. [Google Scholar] [CrossRef] [PubMed]
- Zhu, K.Y.; Palli, S.R. Mechanisms, applications, and challenges of insect RNA interference. Annu. Rev. Entomol. 2020, 65, 293–311. [Google Scholar] [CrossRef] [PubMed]
- Dzitoyeva, S.; Dimitrijevic, N.; Manev, H. Intra-abdominal injection of double-stranded RNA into anesthetized adult Drosophila triggers RNA interference in the central nervous syste. Mol. Psychiatry 2001, 6, 665–670. [Google Scholar] [CrossRef][Green Version]
- Zhou, X.G.; Oi, F.M.; Scharf, M.E. Social exploitation of hexamerin: RNAi reveals a major caste-regulatory factor in termites. Proc. Natl. Acad. Sci. USA 2006, 103, 4499–4504. [Google Scholar] [CrossRef]
- Korb, J.; Weil, T.; Hoffmann, K.; Foster, K.R.; Rehli, M. A gene necessary for reproductive suppression in termites. Science 2009, 324, 758. [Google Scholar] [CrossRef]
- Zhou, X.G.; Wheeler, M.M.; Oi, F.M.; Scharf, M.E. RNA interference in the termite Reticulitermes flavipes through ingestion of double-stranded RNA. Insect Biochem. Mol. Biol. 2008, 38, 805–815. [Google Scholar] [CrossRef] [PubMed]
- Caccia, S.; Astarita, F.; Barra, E.; Leilo, D.I.; Varrichio, P.; Pennacchio, F. Enhancement of Bacillus thuringiensis toxicity by feeding Spodoptera littoralis larvae with bacteria expressing immune suppressive dsRNA. J. Pest Sci. 2020, 93, 303–314. [Google Scholar] [CrossRef]
- Hamilton, C.; Bulmer, M.S. Molecular antifungal defenses in subterranean termites: RNA interference reveals in vivo roles of termicins and GNBPs against a naturally encountered pathogen. Dev. Comp. Immunol. 2012, 36, 372–377. [Google Scholar] [CrossRef]
- Li, S.S.; Hao, Z.P.; Xu, H.H.; Gao, Y.; Zhang, M.Y.; Liang, J.; Dang, X.L. Silencing β-1,3-glucan binding protein enhances the susceptibility of Plutella xylostella to entomopathogenic fungus Isaria cicadae. Pest Manag. Sci. 2022, 78, 3117–3127. [Google Scholar] [CrossRef]
- Saksmerprome, V.; Charoonnart, P.; Gangnonngiw, W.; Withyachumnarnkul, B. A novel and inexpensive application of RNAi technology to protect shrimp from viral disease. J. Virol. Methods 2009, 162, 213–217. [Google Scholar] [CrossRef] [PubMed]
- Huang, Q.Y.; Li, G.H.; Husseneder, C.; Lei, C.L. Genetic analysis of population structure and reproductive mode of the termite Reticulitermes chinensis Snyder. PLoS ONE 2013, 8, e69070. [Google Scholar] [CrossRef] [PubMed]
- Chouvenc, T.; Su, N.Y.; Grace, J.K. Fifty years of attempted biological control of termites–Analysis of a failure. Biol. Control 2011, 59, 69–82. [Google Scholar] [CrossRef]
- Rutledge, R.G.; Cote, C. Mathematics of quantitative kinetic PCR and the application of standard curves. Nucleic Acids Res. 2003, 31, e93. [Google Scholar] [CrossRef]
- Giulietti, A.; Overbergh, L.; Valckx, D.; Decallonne, B.; Bouillon, R.; Mathieu, C. An overview of real-time quantitative PCR: Applications to quantify cytokine gene expression. Methods 2001, 25, 386–401. [Google Scholar] [CrossRef]
- Chen, C.H.; Zheng, Y.J.; Zhong, Y.D.; Wu, Y.F.; Li, Z.T.; Xu, L.A.X.; Xu, M. Transcriptome analysis and identification of genes related to terpenoid biosynthesis in Cinnamomum camphora. BMC Genom. 2018, 19, 550. [Google Scholar] [CrossRef] [PubMed]
- Fraser, A.G.; Kamath, R.S.; Zipperlen, P.; Martinez-Campos, M.; Sohrmann, M.; Ahringer, J. Functional genomic analysis of C. elegans chromosome I by systematic RNA interference. Nature 2000, 408, 325–330. [Google Scholar] [CrossRef] [PubMed]
- Kim, E.; Park, Y.; Kim, Y. A transformed bacterium expressing double-stranded RNA specific to integrin β1 enhances Bt toxin efficacy against a polyphagous insect pest, Spodoptera exigua. PLoS ONE 2015, 10, e0132631. [Google Scholar] [CrossRef]
- Silver, K.; Cooper AM, W.; Zhu, K.Y. Strategies for enhancing the efficiency of RNA interference in insects. Pest Manag. Sci. 2021, 77, 2645–2658. [Google Scholar] [CrossRef]
- Al Baki, A.; Jung, J.K.; Kim, Y. Alteration of insulin signaling to control insect pest by using transformed bacteria expressing dsRNA. Pest Manag. Sci. 2020, 76, 1020–1030. [Google Scholar] [CrossRef]
- Evans, J.D.; Aronstein, K.; Chen, Y.P.; Hetru, C.; Imler, J.L.; Jiang, H.; Kanost, M.; Thompson, G.J.; Zou, Z.; Hultmark, D. Immune pathways and defence mechanisms in honey bees Apis mellifera. Insect Mol. Biol. 2006, 15, 645–656. [Google Scholar] [CrossRef] [PubMed]
- Harrison, M.C.; Jongepier, E.; Robertson, H.M.; Arning, N.; Bitard-Feildel, T.; Chao, H.; Childers, C.P.; Dinh, H.; Doddapaneni, H.; Dugan, S.; et al. Hemimetabolous genomes reveal molecular basis of termite eusociality. Nat. Ecol. Evol. 2018, 2, 557–566. [Google Scholar] [CrossRef] [PubMed]
- Terrapon, N.; Li, C.; Robertson, H.M.; Ji, L.; Meng, X.H.; Booth, W.; Chen, Z.S.; Childers, C.P.; Glastad, K.M.; Gokhale, K.; et al. Molecular traces of alternative social organization in a termite genome. Nat. Commun. 2014, 5, 3636. [Google Scholar] [CrossRef]
- Rath, A.C. The use of entomopathogenic fungi for control of termites. Biocontrol Sci. Technol. 2000, 10, 563–581. [Google Scholar] [CrossRef]
- Yanagawa, A.; Fujiwara-Tsujii, N.; Akino, T.; Yoshimura, T.; Yanagawa, T.; Shimizu, S. Musty odor of entomopathogens enhances disease-prevention behaviors in the termite Coptotermes formosanus. J. Invertebr. Pathol. 2011, 108, 1–6. [Google Scholar] [CrossRef]
- Yanagawa, A.; Fujiwara-Tsujii, N.; Akino, T.; Yoshimura, T.; Yanagawa, T.; Shimizu, S. Odor aversion and pathogen-removal efficiency in grooming behavior of the termite Coptotermes formosanus. PLoS ONE 2012, 7, e47412. [Google Scholar] [CrossRef] [PubMed]
- Rosengaus, R.B.; Jordan, C.; Lefebvre, M.L.; Traniello, J.F. Pathogen alarm behavior in a termite: A new form of communication in social insects. Naturwissenschaften 1999, 86, 544–548. [Google Scholar] [CrossRef] [PubMed]
- Yanagawa, A.; Yokohari, F.; Shimizu, S. Defense mechanism of the termite, Coptotermes formosanus Shiraki, to entomopathogenic fungi. J. Invertebr. Pathol. 2008, 97, 165–170. [Google Scholar] [CrossRef]
- Huvenne, H.; Smagghe, G. Mechanisms of dsRNA uptake in insects and potential of RNAi for pest control: A review. J. Insect Physiol. 2010, 56, 227–235. [Google Scholar] [CrossRef]
- Feng, K.; Li, W.; Tang, X.Y.; Luo, J.; Tang, F. Termicin silencing enhances the toxicity of Serratia marcescens Bizio (SM1) to Odontotermes formosanus (Shiraki). Pestic. Biochem. Physiol. 2022, 185, 105120. [Google Scholar] [CrossRef]
- Franco, T.A.; Oliveira, D.S.; Moreira, M.F.; Leal, W.S.; Melo, A.C.A. Silencing the odorant receptor co-receptor RproOrco affects the physiology and behavior of the Chagas disease vector Rhodnius prolixus. Insect Biochem. Mol. Biol. 2016, 69, 82–90. [Google Scholar] [CrossRef] [PubMed]
Disclaimer/Publisher’s Note: The statements, opinions and data contained in all publications are solely those of the individual author(s) and contributor(s) and not of MDPI and/or the editor(s). MDPI and/or the editor(s) disclaim responsibility for any injury to people or property resulting from any ideas, methods, instructions or products referred to in the content. |
© 2023 by the authors. Licensee MDPI, Basel, Switzerland. This article is an open access article distributed under the terms and conditions of the Creative Commons Attribution (CC BY) license (https://creativecommons.org/licenses/by/4.0/).